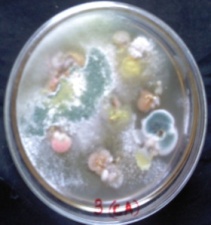
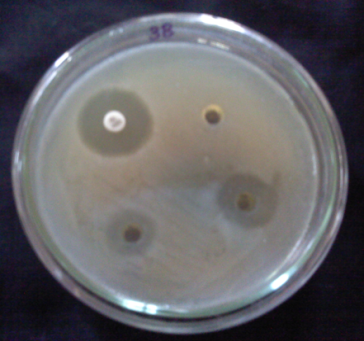
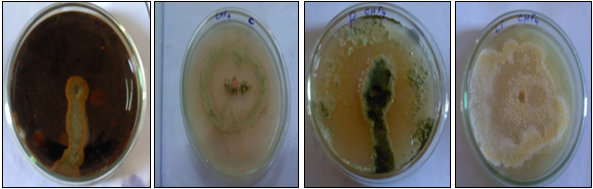

*Research Scholar, Department of Plant Biology and Plant Biotechnology, Ethiraj College for Women (Autonomous), Chennai 600008 Tamil Nadu
Email: **umasezhian@gmail.com
Received: 29 Oct 2015, Revised and Accepted: 30 Dec 2015
ABSTRACT
Objective: Medicinal plants are gaining worldwide attention owing to the fact that the herbal drugs are cost effective, easily available and with negligible side effects. Medicinal plants harbour endophytic microflora and they are valuable source of Bioprospecting endophytes. Endophytes are the microorganisms that inhabit interior of plant tissues that shows no apparent harm to host. Endophytic fungi from medicinal plants are known as “Promising Source” of bioactive novel metabolites which has significant role in pharmacology, agriculture and in industries.
Methods: In our present research work, endophytic fungi were isolated from the leaves of medicinal plant Cardiospermum halicacabum. The frequency of the presence of endophytic fungi was studied based on seasonal variation. Seven endophytic fungi were isolated, of which two isolates were sporulating and identified based on colony morphology, sporulating structures and taken for further studies. The ethyl acetate extract of the isolates were screened for phytochemical studies and also assayed for invitro antibacterial activity. Further, the fungal isolates were checked for their ability to produce extracellular enzymes by qualitative assay and were used to study the presence of chitosan on their cell wall.
Results: The isolates were also screened for extracellular biosynthesis of Silver nanoparticles for which UV-VIS absorption was recorded. FT-IR analysis was also performed to confirm the presence of various functional groups.
Conclusion: The endophytes from Cardiospermum halicacabum can be a potent natural source of bioactive compounds which can be considered to be prolific resource for drugs and as Bioprotectants. Further investigation will focus on the strain improvement and genomic variation among these isolates.
Keywords: Medicinal plants, Endophytic fungi, Bioactive, Phytochemical, Antibacterial, Silver nanoparticles, FT-IR.
© 2016 The Authors. Published by Innovare Academic Sciences Pvt Ltd. This is an open access article under the CC BY license (http://creativecommons.org/licenses/by/4.0/)
INTRODUCTION
Medicinal plants are gaining worldwide attention owing to the fact that the herbal drugs are cost effective, easily available and with negligible side effects. WHO estimate that around 80% of the world’s population uses them in some form or other [1]. Medicinal plants harbor endophytic mycoflora. The choice of the plant to be used for exploring endophytes for bioactive metabolites is important. Therefore, medicinal plants which are known to be used since centuries as an alternative source of medicine are a valuable source of bioprospecting endophytes [2].
Endophytes are the microorganisms that inhabit the interior of plant tissue that shows no apparent harm to the host. Endophytic fungi from medicinal plants are known as “Promising Source” of bioactive novel metabolites which has a significant role in pharmacology, agriculture and in industries. These endophytic fungi are the rich source of functional metabolites such as alkaloids, amines, terpenoids, steroids, flavonoids, phenolic compounds, etc, [3]. Endophytic fungi are known to produce novel antimicrobial agents, anticancer compounds (Taxol) and produce compounds that can be utilized industrially such as enzymes [4]. These endophytic fungi also synthesize silver nanoparticles, metal nanoparticles have promising application in the field of medicine and agriculture, etc.,[5]. There is an increasing effort to characterize and identify endophytic fungi from medicinal plants [6]. There is a need to understand the biodiversity of endophytic fungi and their potential of producing novel compounds of medicinal importance [7].
In the present study, the leaves of Cardiospermum halicacabum, an important medicinal plant, was used for the isolation of endophytic fungi and to evaluate their potential bioactive metabolites. Cardiospermum halicacabum commonly known as ‘Heart Balloon’, ‘seed vine’ and ‘Mudakkatran’, belongs to the family Sapindaceae, is a herbaceous climber of about 2-4m long, evergreen branched with inflated fruits containing white heart-shaped pattern on the seed. It is distributed tropical and subtropical regions of Africa and Asia. It is used for the treatment of rheumatism, lumbago, cough, hyperthermia, nervous diseases, the stiffness of limbs and snake bite [8]. Phytochemical constituents such as flavones, aglycones, triterpenoids, glycosides, range of fatty acids and volatile ester have been reported from various extracts of this plant [9].
While much is known about the phytochemistry of the plant, there is not much information about the presence of endophytes in this plant. Hence, the objective of our present study is to isolate endophytic fungi from the leaves of medicinal plant Cardiospermum halicacabum and to screen the effective metabolites by screening their antimicrobial potential, production of extracellular enzymes, presence of chitosan on their cell wall, synthesis of silver nanoparticles, and FT-IR analysis.
MATERIALS AND METHODS
Collection of plant material
The medicinal plant used in this study, Cardiospermum halicacabum was collected from in and around Chennai. The healthy leaves of the medicinal plants were used for the isolation of endophytes at different seasons such as in the rainy season (November) and late summer (July) to study the seasonal variations of endophytic fungi.
Isolation and identification of endophytic fungi
The healthy leaves were collected and washed under running tap water. The endophytic fungi from the leaves were isolated using standard procedure [10]. The number of individual fungal colonies was counted, and each fungal colony was isolated and subcultured separately to get a pure culture. The morphology of surface texture, pigmentation, and spores at the hyphal tips, were used to identify the different endophytic fungi at species level using standard manual [11]. The endophytic fungi isolated from the host plant collected at two different seasons were analyzed based on Colonization frequency and Percentage of endophytic infection rate (EIR) [12].
Colonization frequency (CF%):
![]()
Endophytic infection rates (EIR %):
![]()
Fermentation and extraction
A 500 ml Erlenmeyer flask containing 200 ml of potato dextrose broth (PDB) was inoculated with 2-3 agar plugs containing mycelia. It was taken from the culture of each endophytic fungal isolate purified on PDA and incubated at room temperature for 15days. The fungal culture was filtered with cheese cloth to remove mycelium and filtrate separately. Both Culture filtrate and mycelia were extracted with ethyl acetate (1:1 ratio) three times. Then the organic phase was evaporated to dryness and finally Culture filtrate extract (CFE) and Culture mycelial extract (CME) were stored for further use.
Preliminary qualitative phytochemical screening
The ethyl acetate extract of the endophytes were checked for the presence of following secondary metabolites such as alkaloids, carbohydrates, phenols, saponins, proteins and amino acids, gum/mucilage, terpenoids by standard procedure [13].
Antimicrobial activity
Different concentrations (50 µl and 100 µl) of both culture filtrate extract (CFE) and culture mycelial extract (CME) were assayed against bacteria such as Bacillus subtilis, Escherichia coli, Pseudomonas aeruginosa, Enterococcus faecalis and Staphylococcus aureus. Assay was carried out using well diffusion method using standard procedure. Muller Hinton Media was used. Gentamycin were used as positive control. The plates were incubated at 37oC. Zone of inhibition around the well was observed after 24 h. Triplicates were maintained for all the samples.
Extracellular enzyme assay
Extracellular enzymes (amylase, cellulase, laccase, lipase and Protease) assay were carried out with standard procedure to investigate the production of enzymes by the endophytic fungi. It was assessed by digestion of (or) dissolved suspended substrate in agar plates after inoculation with 3 mm mycelial plugs and incubation for 3-5 d at 37oC. The diameter of the clear zone was used as a measurement of the amount of enzyme production [14].
Chitosan extraction and purification
Chitosan is a polysaccharide which is found to be present in the cell walls of most species of fungi. Extraction of chitosan from the endophytes were carried out using standard procedure [15]. The chitosan produced from the isolates were characterized in KBr pellets by using an infrared spectrophotometer in the range of 400 to 4000 cm-1.
Extracellular synthesis and characterization of silver nanoparticles from endophytes
For the synthesis of silver nanoparticles, the fungal isolates were grown in 250 ml flask containing 100 ml Potato dextrose broth (PDB) at room temperature for 72 h and then the biomass was harvested and filtered through Whattman filter paper No.1. The fungal mat was washed with distilled water to remove media component and suspended in 100 ml distilled water for 48 h. After 48 h of incubation, the cell filtrate was separated by filtration. The fungal cell filtrate was then collected, and it was challenged with the AgNO3 salt (final conc. 1 mM) [16]. After 24 h of incubation, the formation of silver nanoparticles were screened by visual observation of colour that changes from pale white to brown. Then it was further confirmed by subjecting the reaction mixture to UV–Visible spectrophotometer analysis. The spectrum was scanned at the resolution of 1 nm, between 200–800 nm for each sample.
Fourier transforms infrared spectrophotometric analysis
For the FT-IR study, Spectrum FT-IR system (Shimadzu, IR Affinity 1, Japan), equipped with a DLATGS detector with a mirror speed of 2.8 mm/sec. scan range: from 400-4000 cm-1with a resolution of 4 cm-1was used. The ethyl acetate extract of the endophytes was prepared. The extract was evaporated by the flash evaporator and it was mixed with a KBr salt, using a mortar and pestle and compressed into a thin pellet. Infrared spectra were recorded on KBr pellet on a Shimadzu FTIR spectrometer 4000-500 cm-1.
RESULTS AND DISCUSSION
Isolation and identification of endophytes
A total of seven endophytic fungi has been isolated from the medicinal plant Cardiospermum halicacabum. Three isolates (29%) were sporulating and two isolates were identified as Penicilium funiculosum and Trichoderma viride. Non sporulation forms accounted for 71% of the endophytic population. Hence, further work was carried out only with identified endophytes. (Plate: 1a and 1b). Medicinal plants are reported to harbor endophytes, which in turn provide protection to their host from infectious agents, and they are unexpected producers of metabolites useful in pharmaceutical and agricultural industries. Species composition of endophyte communities of many hosts have shown that a large number of fungal taxa could be isolated from a single host species, of which one or a few fungal species dominate in a host plant [3].

Plate 1a: Inoculation of leaves for isolation of endophytes
Plate 1b: Emergence of endophytic fungi
The endophytic fungal isolate Penicillium funiculosum (CHF1) showed the following characteristic features: colonies spreading with tough basal felt of mycelium and aerial growth with tuft of hyphae. Reverse pink to reddish. conidiophores short, arising from funicles and smooth. Conidia ellipsoidal, smooth. (Plate 2a and 2b).
The endophytic fungal isolate Trichoderma viride (CHF4) showed the following characteristic features: colonies with rapid growth. Initially it formed a white, smooth surfaced and sparse mycelia mat, later aerial hyphae developed on their surface. The conidial area was initially whitish green later turned to bright green. Hyphae septate and branched. The main branch of conidiophore was found to have several lateral branches. (Plate 3a and 3b).
![]() |
![]() |
| Plate 2a: Single colony morphology of P. finiculosum | Plate 2b: Microscopic observation of P. finiculosum |
![]() |
![]() |
| Plate 3a: Single colony morphology of T. viride | Plate 3b: Microscopic observation of T. viride |
The leaves collected during rainy season (November) showed a higher percentage of colonization frequency compared to the leaves collected during late summer (July), but the type of isolates were found to be one and the same in both seasons. Hundred percent Endophytic infection rates was recorded in both season (fig. 1). The distribution of endophytes in a host may be influenced by the environmental factors, (Temperature, edaphic factors, extreme climatic condition, and quality of air) nutrients supplied by the host plant, age of the host plant or tissues and chemicals present in the host plant [17].

Fig. 1: Colonization frequency and Endophytic infection rate of Cardiospermum halicacabum at different season
Antimicrobial activity
The results of the inhibitory action of various concentrations (50 µl, 100 µl) of both culture filtrate extract (CFE) and culture mycelial extract (CME) of both endophytes were tested against bacteria (Bacillus subtilis, Escherichia coli, Pseudomonas aeruginosa, Enterococcus faecalis and Staphylococcus aureus.
Antibacterial activity
The culture filtrate extract of Penicillium funiculosum (CHF1) at 100 µl showed maximum inhibition against Staphylococcus aureus (11±0.3 mm) and minimum inhibition against Enterococcus faecalis (8±0.2 mm). The culture mycelial extract of Penicillium funiculosum (CHF1) at 100 µl showed maximum inhibition against Pseudomonas aeruginosa (16±0.4 mm) and minimum inhibition against Enterococcus faecalis (7±0.2 mm). (Plate: (4a) (fig. 2)
The culture filtrate extract of Trichoderma viride (CHF4) at 100 µl showed maximum inhibition against Bacillus subtilis (14±0.1 mm) and minimum inhibition against E. coli (7±0.2 mm). (Plate 5a) The culture mycelial extract of Trichoderma viride (CHF4) at 100 µl showed maximum inhibition against Bacillus subtilis (10±0.3 mm) and minimum inhibition against enterococcus faecalis (7±0.2 mm) (fig. 3).

Plate 4a: Culture Mycelial extract of P. funiculosum showing maximum zone against P. aeruginosa
Plate 5a: Culture Filtrate Extract of T. viride showing maximum zone against B. subtilis

Fig. 2: Antibacterial activity of culture filtrate extracts (CFE) and culture mycelial extract (CME) of Penicillium funiculosum at 100µg

Fig. 3: Antibacterial activity of culture filtrate extracts (CFE) and culture mycelial extract (CME) of Trichoderma viride. at 100 µg
There is an increasing rate of resistance to existing antibiotics and this problem extends beyond the clinical application of antimicrobial drugs, which includes the microorganisms used in agriculture are known to acquire resistance to commonly used antimicrobial chemicals. The beneficial role of these endophytes may be attributed to the host plant, such as antagonism towards pathogenic bacteria/fungi or decreased susceptibility to phytophagous insects (18). Endophytic fungi have proved to be an important source for bioactive and antimicrobial compounds. They are rich source of functional metabolites such as alkaloids, amines, amides, indole derivatives, steroids, terpenoids, flavonoids, phenols,aliphatic compounds [3].
From the results, it was observed that the two isolates from this host exhibited different strengths of anti microbial activities. The differential susceptibility was attributed to the culture condition, extraction procedure and test strain used for antimicrobial analysis [19].
Our results indicate that the CFE and CME of Penicillium funiculosum and Trichoderma viride have a broad antimicrobial spectrum and strong toxicity of bio active components. The broad antimicrobial spectrum was found to be variable in CFE and CME. Variation between CFE and CME may be due to the production of extra and intracellular metabolites. Similar finding were observed in the reports of antimicrobial activity of Aspergillus sp. isolated from Justicia adathoda [20].
Enzyme assay
Both endophytes Penicillium funiculosum (CHF1) and Trichoderma viride (CHF4) showed the presence of enzymes namely amylase, cellulase, protease and lipase. (Plate 6a and 6b). Laccase activity was found to be absent in both endophytic isolate. (table 2).
Table 2: Extracellular enzyme produced by endophytes
S. No. |
Fungal strain |
Extracellular enzymes |
||||
Amylase |
Cellulase |
Laccase |
Protease |
Lipase |
||
1 |
Penicillium funiuclosum |
+ |
+ |
- |
+ |
+ |
2 |
Trichoderma viride |
+ |
+ |
- |
+ |
+ |

Plate 6a: Enzymes: amylase, cellulase, protease and lipase produced by Penicillium funiculosum
Plate 6b: Enzymes: amylase, cellulase, protease, and lipase produced by Trichoderma viride
Fungal endophytes are gaining importance because of production of enzymes. These fungal enzymes are often more stable (temperature ranges and diverse pH) than enzymes derived from plants and animals. It is useful in agriculture, industries (food processing, production of beverages, textiles and leather industry) and in human health [21].
Presence of amylase activity of the fungal isolates may have industrial and agricultural application with wide spectrum of biological property that can function at diverse pH and temperature ranges. Proteases are used in clinical application especially in the treatments like diabetes [18]. The extra cellular degradative enzyme cellulase observed in fungal isolate may find its application in paper industry. The lipase activity suggests their ability to use fats as energy source [14]. The absence of laccase activity may be attributed to the endophytic nature of these fungi, since an active enzyme may damage the host plant [21].
Chitosan extraction and purification
Both Fungal endophytes Penicillium funiculosum (CHF1) and Trichoderma viride (CHF4) were shown to produce significant quantities of chitosan. The structure of extracted chitosan was confirmed by FTIR analysis. (fig. 4 and 5). In general chitosan shows bands at 3000-3500 cm (NH bond), 1400-1650 (C=O bond) [22].
Chitosan is a polysaccharide which is found to be present within cell walls of most species of fungi [23]. It has been used recently in cosmetics, pharmaceuticals, food additives and agriculture. The natural antibacterial and antifungal characteristic of chitosan and its derivatives have resulted in their use in commercial disinfectants. It has been shown to activate the defense system of the host and prevent the invasion of pathogens. Hence, the production of chitosan from endophytic fungi can be used as an alternative source to production from shells of crustaceans [15]. Chitosan is naturally occurring compound that have potential in agriculture in controlling plant diseases. Chitosan is one of the most studied elicitors which have the eliciting activities. It regulates the expression of resistance genes leading to defense response [24].

Fig. 4: FTIR spectrum for chitosan of P. funiculosum

Fig. 5: FTIR Spectrum for chitosan of T. viride
Synthesis of silver nanoparticles by fungal endophytes
The biosynthesis of nanoparticles by microbes is thought to be clean, nontoxic, and environmentally acceptable “green chemistry” procedures. Fungi, the biofactories of nanoparticles have taken the centre stage in biological metal particles generation due to their tolerance and bioaccumulation ability of metals. Their efficacy in the production of enzymes on a large scale, the ease of handling biomass makes it a model system for nanoparticle synthesis [25]. Silver nanoparticles are synthesized from endophytic fungi and they possess antimicrobial activity.
The rapid colour change of dark brown in both fungal cell filtrates (after 24 h) with the addition of silver nitrate solution was observed from our results. The appearance of a colour change indicates the synthesis of silver nanoparticles. (Plate: 7a and 7b). The formation of silver nanoparticles in fungal cell filtrate was further characterized by using UV-VIS Spectrophotometer. The reaction mixture of Penicillium funiculosum showed peak at 452 nm and Trichoderma viride showed a sharp peak at 439 nm. (fig. 6, 7)

Plate 7a: Colour change observed after addition of AgNO3 from P. funiclosum

Plate 7b: Colour change observed after addition of AgNO3 from T. viride
C-Control (Fungal cell filtrate before treatment of AgNo3). 1-Fungal cell filtrates after treatment of AgNo3

Fig. 6: UV Vis Spectra of silver nanoparticles by Penicillium funiculosum showing peak at 452 nm

Fig. 7: UV Vis Spectra of silver nanoparticles by Trichoderma viride showing peak at 439 nm
The characteristic brown colour arises due to the excitation of surface Plasmon vibrations in silver nanoparticles [25]. The mechanism of silver nanoparticles production by fungi is due to trapping of Ag+ions at the surface of the fungal cells and the subsequent reduction of the silver ions by the enzyme present in the fungal system [15]. The use of eukaryotic organisms such as fungi holds the promising tool for the large-scale production of metal nanoparticles as the enzymes secreted by fungi is an essential element for the biosynthesis of metal nanoparticles. The metallic nanoparticles are most promising as they contain remarkable antibacterial properties due to their large surface area to volume ratio [26]. Most of the nanoparticles are used in various fields such as optical devices, catalytic, bactericidal, electronic, sensor technology, biological labeling and treatment of some cancers. Silver nanoparticles are known to be used as antimicrobial agents, in textile industries, for water treatment, in sunscreen lotions, etc., [27].
Phytochemical analysis
The results of qualitative phytochemical analysis indicate that the ethyl acetate extract of both endophytes contains alkaloids, carbohydrates, proteins, phenolic compounds and tannins. (table 3).
The presence of phytochemicals within the endophytes can be a potential source for medicinal and industrial use and it is also an indicator that they can be a potential source of precursors in the development of synthetic drugs. Phytochemical screening serves as the initial step in predicting the types of potential bioactive metabolites in the extract [28].
Table: 3 Phytochemical test for endophytes
| S. No. | Phytochemical tests | P. funiculosum | T. viride |
| 1 | Alkaloid test Mayer’s test Wagner’s test Dragendroff’s test |
+ + - |
+ - - |
| 2 | Carbohydrates and glycosides test Fehling’s test Barfoed’s test Benedict’s test |
+ - - |
- + + |
| 3 | Saponin test | - | - |
| 4 | Protein and amino acid tests Million’s test Biuret test Ninhydrin test |
+ - - |
- + + |
| 5 | Fixed oils and fats Spot test |
- | - |
| 6 | Phenolic compounds and tannins Ferric chloride test Lead acetate test Alkaline reagent test |
+ - - |
- + - |
| 7 | Gum and mucilage | - | - |
| 8 | Terpenoid (Salkowski test) | - | - |
FT-IR analysis
(fig. 8 and 9) FT-IR spectra of culture filtrate extract of both fungal isolates indicate the presence of alkyl halides, carboxylic acids, aliphatic amines, alkanes, primary amines, esters, aromatics, nitro compounds, and aldehydes.

Fig. 8: FT IR spectrum of culture filtrate extract of Penicillium funiculosum

Fig. 9: FTIR spectrum of culture filtrate extract of Trichoderma viride
FT-IR analysis of the two endophytic isolates revealed the distribution of functional group within the organic fractions. The presence of various functional groups may be attributed to the existence of a variety of potential phytochemicals [29].
CONCLUSION
In conclusion, the present study reveals that the endophytic fungi Penicillium funiculosum and Trichoderma viride isolated from the medicinal plant Cardiospermum halicacabum showed the presence of potent antimicrobial activity, capable of producing enzymes, synthesizing silver nanoparticles and revealed the production of various phytochemicals and chitosan. The endophytes from Cardiospermum halicacabum can be a potent natural source of bioactive compounds which can be considered to be prolific resource for drugs and as Bioprotectants. Further investigation will focus on the strain improvement and genomic variation among these isolates.
ACKNOWLEDGEMENT
The author thanks Mrs. Prema Sampathkumar, Associate professor and Head, Dr. Mrs Shyamala Kanakarajan (Former Head), the Faculty members and non teaching staff of the Department of Plant Biology and Plant Biotechnology, Dr. Mrs A. Nirmala Principal Ethiraj College for Women, (autonomous) Chennai 600008, for their valuable support and encouragement throughout the entire period of research. We would also like to express our thanks for the facilities extended by the Central Instrumentation centre of Ethiraj College for Women.
CONFLICT OF INTERESTS
Declare none
REFERENCES